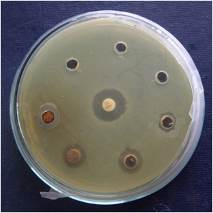
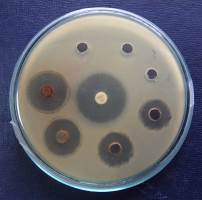
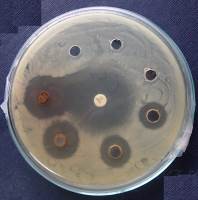
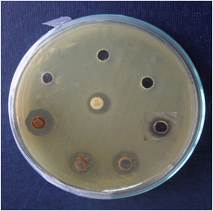
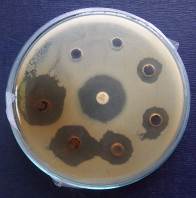
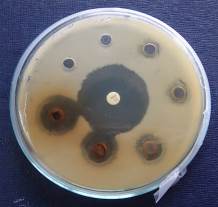
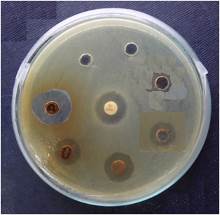
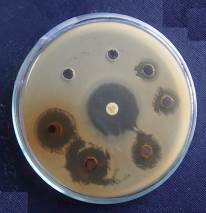
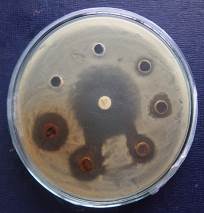
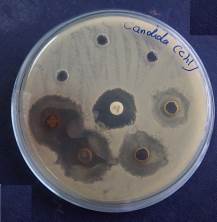
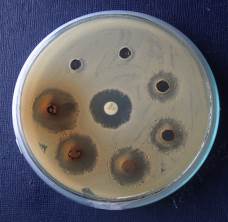

Int J Curr Pharm Res, Vol 7, Issue 3, 60-63Original Article
EVALUATION OF ANTIMICROBIAL STUDIES ON ROOT OF CARMONA RETUSA (VAHL) MASAM
S Mageswari*, S Karpagam
Associate Professor, Dept. of Botany, Queen Mary’s College, Chennai
Email: mageswari0204@gmail.com
Received: 30 May 2015, Revised and Accepted: 30 Jun 2015
ABSTRACT
Objective: The evaluation of antimicrobial activity was carried to study the effect of root extract of Carmona retusa (Vahl.) Masam.
Methods: The antimicrobial studies were carried out by using the cup plate method and the MIC was also determined. The microbial typed cultures namely Bacillus cereus, Bacillus subtilis, Enterobacter aerogens, Escherichia coli, Klebsiella pneumonia, Pseudomonas aeruginosa, Pseudomonas putida, Staphylococcus aureus, Salmonella typhimurium and Candida albicans were used.
Results: The root extracts of both chloroform and alcohol showed promising activity against Bacillus subtilis (26 mm), Bacillus cereus and Candida albicans (24 mm), Pseudomonas putida and Staphylococcus aureus (20 mm) and Escherichia coli (18 mm).
Conclusion: The study revealed that the antimicrobial activity of alcohol extract is comparatively higher than the chloroform extract.
Keywords: Antimicrobial, Carmona retusa.
INTRODUCTION
Infectious diseases are considered as the major cause of morbidity and mortality. In recent years drug resistant to human pathogenic bacteria has been commonly reported from all over the world. In addition to this problem, antibiotics are sometimes associated with adverse effects on the host which include hypersensitivity, depletion of beneficial gut and mucosal microorganisms, immune suppression and allergic reactions. This has created immense clinical problem in the treatment of infectious diseases. Therefore there is a need to develop alternative antimicrobial drugs to fight against emerging and reemerging infectious disease [1].
Several hundreds of plants are used medicinally as herbal preparations in the indigenous system of medicine in different countries [2]. India has more than one fourth (8000) of the world’s known medicinal plant species (30,000), of which 90% are found in forests [3]. Plant species still serves as the rich source of many novel biological active compounds, as very few plants species have been thoroughly investigated for their medicinal properties [4].
Many plants have limitless ability to synthesize secondary metabolites of which at least 12000 have been isolated. Many plants and their extracts/compounds were used against various microbial infections due to the presence of various secondary metabolites such as flavones, flavonoids, flavonols, tannins, coumarins, terpenoids, essential oils, alkaloids, lectins and polypetptides, mixtures and other compounds [5].
Carmona retusa (Vahl.) Masam., Family–Boraginaceae, previously known as Ehretia microphylla Lam. The only species of Carmona retusa is found Southern Asia from India to Taiwan and the Philippine Islands and Eastwards to New Guinea and the Soloman Islands [6].
Carmona retusa (Vahl.) Masam (Ehretia microphylla Lam.) is reported to be medicinally useful in Indigenous System of Medicine [7]. This plant is also recorded as Kuruvichi, or Kuruvichi poondu in Siddha Materia Medica [8, 9]. It is used for leprosy, eczema due to venereal diseases, chronic dysentery, infertility and toxic diarrhea in children. It is widely used in the Philippines as herbal medicines; the leaves are used to treat cough, colicdiarrhea and dysentery [10].
A novel natural product microphyllone has been isolated from Ehretia microphylla together with baurenol and ursolic acid [11]. Astragalin, nicotoflorin, bauerenol, α-amyrin, β-amyrin were also isolated from this plant [12]. The roots of the plants are used in southern India for Cachexia and syphilis and as an antidote for certain plant poisons [13, 14]. E. microphylla promote the pituitary-ovary axis activities and cause an elevation in the serum concentrations of LH, FSH and estradiol hormones as well as increase the mean numbers of follicles and eventually ovarian weight [15].
Penecilla and Magno [16] reported that the extract of aerial part of C retusa showed antibacterial activity against Staphylococcus aureus, Bacillus subtilis and Pseudomonas aeruginosa whereas there is no activity against Escherichia coli. Chandrappa et al., [17] also reported that the stem extract showed antibacterial activity against Pseudomonas aeruginosa, Klebsiella pneumonia, Shigella flexnari and Bacillus subtilis.
As there are is no report on the root, with this view, an investigation was initiated to study the antimicrobial activity of the root extract.
MATERIALS AND METHODS
The root of the plant C. retusa was collected from Chengalpattu District, Tamil Nadu, and India. The plant specimen was identified and authenticated by Prof. DR. P. Jayaraman, Plant Anatomy Research Centre, West Tambaram, Chennai-45.
Extract preparation
The collected root samples were shade dried and coarsely powdered. The coarsely powdered root materials were extracted with chloroform and alcohol at room temperature (48 hrs) separately and filtered using Whatmann No.1 filter paper. The filtrates were concentrated on the water bath and finally in vacuum. The thick brown mass of both the chloroform and alcoholic extracts of C. retusa were stored in air tight container at 4 °C till further use.
Drug concentration
The chloroform and alcohol extracts of C. retusa root was weighed accurately 500 mg and dissolved in 1 ml of dimethyl sulphoxide (DMSO) [18] to make the stock solution containing 500 mg/ml. Serial dilution was prepared from the stock solution to get the concentration of 100mg/ml, 50mg/ml, 25mg/ml, 12.5mg/ml, 6.25mg/ml, 3.125mg/ml and 1.5625mg/ml.
Cultures used for the study
The microbial typed cultures namely Bacillus cereus (NCIM 2458), Bacillus subtilis (NCIM 2197), Enterobacter aerogens (NCIM 5139), Escherichia coli (NCIM 2931), Klebsiella pneumonia (NCIM 2957), Pseudomonas aeruginosa (NCIM 2945), Pseudomonas putida (NCIM 2847), Staphylococcus aureus (NCIM 5021), Salmonella typhimurium (NCIM 2501) and Candida albicans (NCIM 3471) were procured from NCIM (National Collection of Industrial Microorganisms), Pune. All the bacterial and fungal organisms were confirmed using specific staining and biochemical tests [19, 20].
Antimicrobial activity
The antimicrobial activity of the plant was performed using the cup plate method [21]. The required quantities of the Muller Hinton agar medium were prepared. The pH of the medium was adjusted to 7.2. Each plate was poured with 20 ml of the media and was allowed to solidify. The tubes containing microbial cultures were dipped with sterile cotton swabs; the excess of the fluid was removed by gently rotating the swabs against the sides of the test tube. The dipped swabs were swabbed over the Muller Hinton agar plates covering the entire surface of the plate by rotating the plates in all the directions. The plates were allowed to stand for the few minutes. The required numbers of 6 mm diameter wells were made using the agar gel borer at an equidistant position. Commercially available disc of ampicillin was used as standard.
Wells was loaded with 60 µl of chloroform and alcohol root extracts of C. retusa (100mg/ml). All the plates were incubated carefully without any disturbance at 37 °C for 24 hrs. The zone of inhibition was measured using the caliper.
Minimum inhibitory concentration (MIC)
The MIC, the lowest concentration of the drug required to inhibit the microorganism was also determined by the agar diffusion method [20]. Petri dishes containing 20 ml of Muller Hinton agar media were prepared and swabbed with uniformly grown log phase cultures of above mentioned organisms. The plates were allowed to stand for few minutes. The required numbers of 6 mm diameter wells were made using the agar gel borer and 60 µl of increasing concentration of the drug 1.5625mg/ml, 3.125mg/ml, 6.25mg/ml, 12.5mg/ml, 25mg/ml, 50mg/ml and 100mg/ml of the extracts were added and the plates were incubated at 37 °C for 24 hrs. The lowest concentration of the drug that completely inhibits the growth was determined after overnight incubation at 37 °C.
 |
 |
 |
|
| Bacillus cereus NCIM 2458 | Bacillus subtilis NCIM 2197 | Escherichia coli | Klebsiella pneumoniae |
|
|
|
|
| Pseudomonas putida | Staphylococcus aureus | Salmonella typhimurium |
Fig. 1: Chloroform extract showing antibacterial activity
|
 |
|
|
| Bacillus cereus NCIM 2458 | Bacillus subtilis NCIM 2197 | Escherichia coli | Klebsiella pneumoniae |
|
|
 |
|
| Pseudomonas putida | Staphylococcus aureus | Salmonella typhimurium |
Fig. 2: Chloroform extract showing antibacterial activity
|
|
|
| Candida albicans | Candida albicans |
Fig. 3: Chloroform and Alcohol extract showing anticandidal activity
Table 1: Antimicrobial activity of Carmona retusa root extract
| S. No. | Name of the Organisms | Extracts | Standard | 100mg/ml | 50mg/ml | 25mg/ml | 12.5mg/ml | 6.25mg/ml | 3.125mg/ml | 1.56mg/ml |
| 1 | Bacillus cereus NCIM 2458 | Ch | 30 | 24 | 22 | 18 | 12 | - | - | - |
| Al | 22 | 24 | 18 | 16 | 14 | 12 | - | - | ||
| 2 | Bacillus subtilis NCIM 2197 | Ch | 40 | 26 | 22 | 16 | 14 | - | - | - |
| AL | 40 | 26 | 20 | 14 | 12 | - | - | - | ||
| 3 | Enterobacter aerogens NCIM 5139 | Ch | - | - | - | - | - | - | - | - |
| Al | - | - | - | - | - | - | - | - | ||
| 4 | Escherichia coli NCIM 2931 | Ch | 30 | 18 | 14 | 12 | 10 | - | - | - |
| Al | 30 | 18 | 14 | 12 | 10 | 8 | - | - | ||
| 5 | Klebsiella pneumonia NCIM 2957 | Ch | 14 | 13 | 10 | 9 | 8 | - | - | - |
| Al | 14 | 18 | 14 | 12 | 10 | 8 | - | - | ||
| 6 | Pseudomonas aeruginosa NCIM 2945 | Ch | - | - | - | - | - | - | - | - |
| Al | - | - | - | - | - | - | - | - | ||
| 7 | Pseudomonas putida NCIM 2847 | Ch | 24 | 20 | 16 | 15 | 14 | |||
| Al | 24 | 18 | 16 | 14 | 10 | 8 | ||||
| 8 | Staphylococcus aureus NCIM 5021 | Ch | 30 | 20 | 18 | 14 | 12 | - | - | - |
| Al | 32 | 16 | 14 | 12 | 10 | 8 | ||||
| 9 | Salmonella typhimurium NCIM 2501 | Ch | 10 | 12 | 10 | 9 | 8 | - | - | - |
| Al | 10 | 16 | 14 | 12 | 10 | 8 | ||||
| 10 | Candida albicans NCIM 3471 | Ch | 18 | 24 | 22 | 20 | 18 | - | - | - |
| Al | 18 | 18 | 16 | 14 | 12 | 10 | - | - |
RESULTS AND DISCUSSION
The results of the antimicrobial activity and MIC of the drug for all the organisms were observed and tabulated (table-1). A significant growth inhibition was shown by most of the organisms tested indicating the profound potency of the drug. Among the 10 microorganisms were tested Bacillus subtilis (26 mm), Bacillus cereus (24 mm), Candida albicans (24 mm), Pseudomaonas putida (20 mm), Staphylococcus aureus (20 mm) and Escherichia coli (18 mm) showed a zone diameter ranging at various concentration of the root extracts. The MIC was also determined for the sensitive organisms (MIC Conc. 50mg/ml to 1.56mg/ml). The species of Klebsiella pneumonia and Salmonella typhimurium showed only minimum sensitivity to both the extracts. No activity was observed in the organisms Enterobacter aerogenes and Pseudonmonas aerogenes.
Among the 10 microorganisms tested Bacillus subtilis was found to be the most sensitive organisms with 26 mm diameter followed by Bacillus cereus and Candida albicans (24 mm), Pseudomonas putida and Staphylococcus aureus (20 mm) and Escherichia coli and Klebsiella pneumonia (18 mm) at the concentration of 100 mg/ml for chloroform and alcohol extract of the plant. On comparison the alcoholic root extracts of C. retusa exhibited relatively good inhibition against most of the organisms (6.25 mg/ml) tested than the chloroform extract.
The screening of natural products has been the source of innumerable therapeutic agents [22]. The selection of crude plant extracts for screening programs is potentially more successful in initial steps than the pure compounds [23]. Natural products either extract or pure compounds provide unlimited opportunities for the development of new drugs due to the availability of chemical diversity [24].
Higher plants as a source for new potential drugs is still largely unexplored and only a small percentage of them have been subjected to phytochemical investigation. Such screening of various natural organic compounds and identifying active agents is a need of the hour as due to the successful prediction of lead molecule and drug like properties at the onset of drug discovery will pay of later in drug development [25]. Such screening of various plant extracts has been previously studied by many workers [26, 27].
It is well known that even the most synthetic drugs have their origin from plant products.
CONCLUSION
This study concludes plant extracts can be used as alternative drugs to treat the diseases caused by pathogens. Further studies are needed with this plant to isolate, characterize and elucidate the structure of the bioactive compounds of this plant for industrial drug formulation. The studies on plant extract could be an answer to the people seeking for better therapeutic agents from natural sources which is believed to be more efficient with little or no side effects when compared to the commonly used synthetic chemotherapeutic agents.
REFERENCES
- Rawat Mukesh, Parmar Namita. Medicinal plants used as antimicrobial agents: a review. Int Res J Pharm 2012;3(1):31-40.
- Heinrich, Gibbons. Ethnopharmacology in drug discovery, an analysis of its role and potential contribution. J Pharm Pharmacol 2001;53:425-32.
- Krishna Kumar A, Katakam A. Credit for conservation. Frontline 2002;19:9-22.
- Agarwal RB, Rangari VD, Singhania SS. Antibacterial and antifungal activity studies of oil of Strobilanthus ixiocephala. Indian Drugs 2002;39(1):36-8.
- Marjorie Murphy Cowan. Plant products as antimicrobial agents. Clin Microbiol Rev 1999;12(4):564-82.
- Dassanayake MD. A revised handbook to the flora of Ceylon. Oxford & IBH Publishing Company Private Limited: New Delhi; 1991;7:3-6.
- Chopra RN, Nayar SL, Chopra IC. Glossary of indian medicinal plants. Council of Scientific and Industrial Research, New Delhi; 1980. p. 104.
- Murugesa Mudaliyar KS. Gunapadam. Part-I. Chennai, Tamil Nadu Siddha Medical Board; 1956. p. 274.
- Kannusamy Pillai C. Pathartha Guna Vilakkam. Chennai: B Rathina Nayakar & Sons; 1939. p. 265-6.
- Starr F, Starr K, Loope L. Carmona retusa, United States Geological Survey—Biological Resources; 2003. p. 1-4.
- Ram P Rastogi, BN Mehrotra. Compendium of indian medicinal plants. Vol. III. (1980-1984), Central Drug Research Institute, Lucknow, Publications & Informations Directorate, New Delhi; 1993. p. 136-7, 260-1.
- Rimando AM, Inoshiri S, Otsuka H, Kohda H, Yamasaki K, Padolina WG, et al. Screening for mast cell Histamine release inhibitory activity of Philippine. Med Plants Active Constituents of Ehretia Microphylla–Shoyakugakuzasshi 1987;41(3):242–7.
- De Padua L, Lugod G, Pancho J. Handbook on philippine medicinal plants. Vol. 1. Documentation and Information Section, Office of the Director of Research, UPLB, Philippines1977. p. 21.
- Quisumbing E. Medicinal Plants of the Philippines, Katha Publishing Co, Inc. Philippines; 1978. p. 773.
- Aarthi I, Anbu JKFH Nazeer Ahamed, Ashwini Anjana, Velpandian V. Effect of Ehretia microphylla Lamk. On stimulation of reproductive function and ovarian folliculogenesis in rats. Int J Pharma Bio Sci 2012;3(3):273–80.
- Penecilla G, Magno C. Antibacterial activity of extracts of twelve common medicinal plants from the Philippines. J Med Plants Res 2011;5(16):3975-81.
- Chandrappa CP, Govindapa M, Anil Kumar NV. Phytochemical screening and antibacterial property of Carmona retusa (Vahl.) Masam. Int J Pharma Med Biol Sci 2012;1(2):91-8.
- Divakar CM, Nair GRN. Antiulcer, Antibacterial and spermicidal activities of Salanin. Indian Drugs 2001;38(2):629-32.
- Mackie, Mac Cartney. Practical Microbiology. Churchill Livingston Publishers; London; 1996. p. 131, 851.
- Myer, Koshi. Manual of diagnostic procedures in medical microbiology and immunology and serology, Christian Medical College and Hospital. Vellore 1982;72:109.
- Barry. The Antimicrobial Susceptibility Test: Principles and Practices. Lea and Febiger, Philadelphia; 1976.
- Suresh G, Ramesh B, Kavitha K, Ravichandran NR, Suresh A, Gopalakrishnaan V, et al. Preliminary screening of antibacterial compounds from Palarriver basin flora. J Phytol 2010;2(2):24-9.
- Kasamota IT, Nakabayasi T, Kida H. Screening of various plant extracts used in Ayurvedic medicine for inhibitory effects on human immune deficiency virus type I (HIV-protease). Phytother Res 1995;9:180-4.
- Cos P, Vilietinck AJ, Vanden Berghe D, Maes L. Anti-infective potential of natural products: how to develop a stronger in vitro proof-of concept. J Ethanopharmacol 2006;106:290-302.
- Maluventhan Viji, Sangu Murugesan. Phytochemical analysis and antibacterial activity of medicinal plant Cardiopsermum helicacabum Linn. J Phytol 2010;2(1):68–77.
- Erdogrul OT. Antimicrobial activities of some plant extracts used in folklore medicine. Pharm Biol 2002;40:269-73.
- Parek J, Karathia N, Chandra S. Screening of some traditionally used medicinal plants for potential antibacterial activity. Indian J Pharm Sci 2006;68(6):832-4.